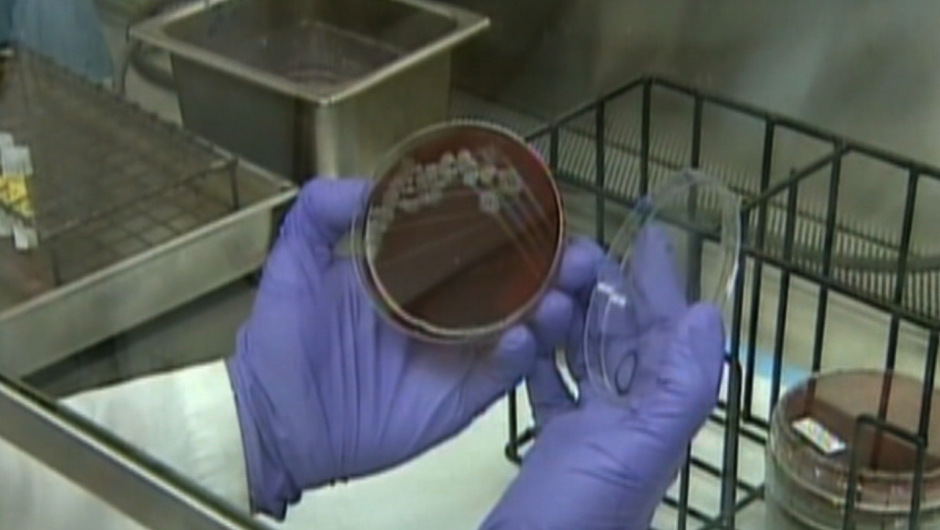
Post thumbnail

Laboratorio militar de EE.UU. envía por error paquetes de ántrax vivo
Cuatro trabajadores del Departamento de Defensa en Estados Unidos y hasta 22 personas en el extranjero están bajo tratamiento postexposición después de que se dio a conocer que un laboratorio militar ...
Cuatro trabajadores del Departamento de Defensa en Estados Unidos y hasta 22 personas en el extranjero están bajo tratamiento postexposición después de que se dio a conocer que un laboratorio militar de Utah envió por error muestras de ántrax vivo en los últimos días, dijo un funcionario de defensa.
Las muestras de ántrax deben matarse antes de ser enviadas, bajo la rutina seguida en los programas de investigación. Provinieron de un laboratorio militar en Dugway, Utah, según informaron dos funcionarios de defensa estadounidense.
Las muestras llegaron a laboratorios de nueve estados del país y a un laboratorio de capacitación en una base situada en Corea del Sur, informó el portavoz del Pentágono, el coronel Steve Warren.
Expertos del Departamento de Defensa dijeron que no había riesgo para el público. Sin embargo, cuatro trabajadores en los nueve estados que recibieron los envíos se han puesto bajo el tratamiento posterior a la exposición, ya que manejan muestras.
“La muestra fue destruida de acuerdo con protocolos adecuados”, dijo Warren.
Hasta 22 personas fueron expuestas en el laboratorio en Corea del Sur, según un comunicado de la base Osan.
“A todo el personal se le proporcionaron las medidas médicas cautelares apropiadas, que incluyen exámenes, antibióticos y, en algunos casos, vacunas”, dijo el comunicado. “Ninguno de los miembros del personal mostró signos de una posible exposición.”
La instalación fue descontaminada después y el ántrax destruido.
El ántrax, también conocido como carbunco, es provocado por la bacteria Bacillus anthracis y se transmite cuando los seres humanos con heridas tienen contacto con la bacteria, respiran sus esporas o ingieren carne de animales infectados, estos últimos dos casos, son de mayor peligrosidad.
Hasta ahora no se conoce de casos de transmisión entre personas, según el Centro para el Control y la Prevención de Enfermedades (CDC) en Estados Unidos.
En 1979, en Rusia se desarrolló una variedad extremadamente peligrosa de esta enfermedad que cobró la muerte de casi un centenar de personas.
CNN











